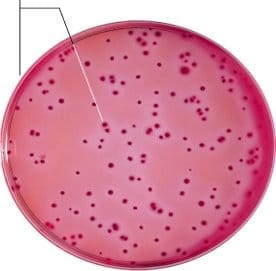
Violet Red Bile Glucose Agar  gotowa pożywka na płytkach kontaktowych

Znaleziono produktów: 287
Tryptone Soya Bulion USP gotowa pożywka w probówkach

• Opakowanie: 50 x 10 ml
• Wyrób medyczny: Tak
TZP 110 Piperacillin/Tazobactam, krążki antybiotykowe, op.=5x50 krążków

Krążki antybiotykowe
Produkt kompatybilny z: Dyspenser do nanoszenia krążków
Ilość szt. W opakowaniu: 5x50 szt.
Wyrób medyczny: Tak
TZP 36 Piperacillin/Tazobactam, krążki antybiotykowe, op.=5x50 krążków

Krążki antybiotykowe
Produkt kompatybilny z: Dyspenser do nanoszenia krążków
Ilość szt. W opakowaniu: 5x50 szt.
Wyrób medyczny: Tak
UB 30 Flumequine, krążki antybiotykowe, op.=5x50 krążków

Krążki antybiotykowe
Produkt kompatybilny z: Dyspenser do nanoszenia krążków
Ilość szt. W opakowaniu: 5x50 szt.
VA 30 Vancomycin, krążki antybiotykowe, op.=5x50 krążków

Krążki antybiotykowe
Produkt kompatybilny z: Dyspenser do nanoszenia krążków
Ilość szt. W opakowaniu: 5x50 szt.
Wyrób medyczny: Tak
VA 5 Vancomycin, krążki antybiotykowe, op.=5x50 krążków

Krążki antybiotykowe
Produkt kompatybilny z: Dyspenser do nanoszenia krążków
Ilość szt. W opakowaniu: 5x50 szt.
Wyrób medyczny: Tak
Violet Red Bile Glucose Agar gotowa pożywka na płytkach kontaktowych
Violet Red Bile Glucose Agar na Płytkach Kontaktowych. Podłoże selektywne zawierające glukozę do wykrywania i oznaczania liczby Enterobacteriaceae na powierzchniach.
• Rozmiar płytek: 55 mm
• Opakowanie: 2 x 5 sztuk
VOR 1 Voriconazole, krążki antybiotykowe, op. 5x50 krążków

Krążki antybiotykowe
Produkt kompatybilny z: Dyspenser do nanoszenia krążków
Ilość szt. W opakowaniu: 5x50 szt.
Wyrób medyczny: Tak
W 1.25 Trimethoprim, krążki antybiotykowe, op.=5x50 krążków

Krążki antybiotykowe
Produkt kompatybilny z: Dyspenser do nanoszenia krążków
Ilość szt. W opakowaniu: 5x50 szt.
Wyrób medyczny: Tak
W 5 Trimethoprim, krążki antybiotykowe, op.=5x50 krążków

Krążki antybiotykowe
Produkt kompatybilny z: Dyspenser do nanoszenia krążków
Ilość szt. W opakowaniu: 5x50 szt.
Wyrób medyczny: Tak
darmowa i wygodna wysyłka
już od 800 zł netto
Najwyższa jakość
produktów potwierdzona certyfikatami
Zakupy 24h na dobę
wygodne i bezpieczne
bezpłatna konsultacja
z ekspertem online


